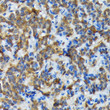
Immunohistochemistry analysis of paraffin-embedded human thyroid cancer using Thyroid Peroxidase Rabbit monoclonal antibody (STJ11103933) at dilution of 1:100 (40x lens). Perform microwave antigen retrieval with 10 mM Tris/EDTA buffer pH 9. 0 before commencing with immunohistochemistry staining protocol.

Anti-TPO antibody (1-100) [S3933RM] (STJ11103933)
SPECIFICATIONS
ClonalityMonoclonal
HostRabbit
ConjugationUnconjugated
IsotypeIgG
General Information
| Short Description | Rabbit monoclonal Thyroid Peroxidase (1-100) antibody for use in IHC-P and ELISA in human, mouse and rat samples. Datasheet included with dilution recommendations, and related reagents. |
| Applications | IHC-P/ELISA |
| Host | Rabbit |
| Reactivity | Human/Mouse/Rat |
| Note | STRICTLY FOR FURTHER SCIENTIFIC RESEARCH USE ONLY (RUO). MUST NOT TO BE USED IN DIAGNOSTIC OR THERAPEUTIC APPLICATIONS. |
Product Properties
| Clonality | Monoclonal |
| Clone ID | S3933RM |
| Isotype | IgG |
| Conjugation | Unconjugated |
| Concentration | Lot specific |
| Purification | Affinity purification |
| Dilution Range | IHC-P:1:50-1:200ELISA:Recommended starting concentration is 1 Mu g/mL. Please optimize the concentration based on your specific assay requirements. |
| Formulation | PBS with 0.02% Sodium Azide, 0.05% BSA, 50% Glycerol, pH 7.3. |
| Storage Instruction | Store at-20°C for up to 1 year from the date of receipt, and avoid repeat freeze-thaw cycles. |
Target Information
| Gene Symbol | TPO |
| Gene ID | 7173 |
| Uniprot ID | PERT_HUMAN |
| Immunogen Region | 1-100 |
| Immunogen Sequence | MRALAVLSVTLVMACTEAFF PFISRGKELLWGKPEESRVS SVLEESKRLVDTAMYATMQR NLKKRGILSPAQLLSFSKLP EPTSGVIARAAEIMETSIQA |
| Specificity | A synthetic peptide corresponding to a sequence within amino acids 1-100 of human Thyroid Peroxidase (P07202). |
Additional Info
| Post Translational Modifications | Glycosylated. Heme is covalently bound through a H(2)O(2)-dependent autocatalytic process. Heme insertion is important for the delivery of protein at the cell surface. Cleaved in its N-terminal part. |
| Function | Iodination and coupling of the hormonogenic tyrosines in thyroglobulin to yield the thyroid hormones T(3) and T(4). |
| Protein Name | Thyroid PeroxidaseTpo |
| Database Links | Reactome: R-HSA-209968 |
| Cellular Localisation | MembraneSingle-Pass Type I Membrane ProteinIsoform 3: Cell Surface |
| Alternative Antibody Names | Anti-Thyroid Peroxidase antibodyAnti-Tpo antibodyAnti-TPO antibody |
Information sourced from Uniprot.org